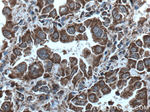
cIAP1 Antibody in Immunohistochemistry (Paraffin) (IHC (P))

Search
Proteintech
cIAP1 Monoclonal Antibody (1H3F1)
{{$productOrderCtrl.translations['antibody.pdp.commerceCard.promotion.promotions']}}
{{$productOrderCtrl.translations['antibody.pdp.commerceCard.promotion.viewpromo']}}
{{$productOrderCtrl.translations['antibody.pdp.commerceCard.promotion.promocode']}}: {{promo.promoCode}} {{promo.promoTitle}} {{promo.promoDescription}}. {{$productOrderCtrl.translations['antibody.pdp.commerceCard.promotion.learnmore']}}
产品信息
66626-1-IG
种属反应
已发表种属
宿主/亚型
分类
类型
克隆号
抗原
偶联物
形式
浓度
规格
纯化类型
保存液
内含物
保存条件
运输条件
产品详细信息
Immunogen sequence: LGDSPIQKH KQLYPSCSFI QNLVSASLGS TSKNTSPMRN SFAHSLSPTL EHSSLFSGSY SSLSPNPLNS RAVEDISSSR TNPYSYAMST EEARFLTYHM WPL (95-196 aa encoded by BC016174)
靶标信息
The protein encoded by this gene is a member of a family of proteins that inhibits apoptosis by binding to tumor necrosis factor receptor-associated factors TRAF1 and TRAF2, probably by interfering with activation of ICE-like proteases. This encoded protein inhibits apoptosis induced by serum deprivation and menadione, a potent inducer of free radicals.
仅用于科研。不用于诊断过程。未经明确授权不得转售。
生物信息学
蛋白别名: apoptosis inhibitor 1; apoptosis inhibitor 2; baculoviral IAP repeat-containing 3; Baculoviral IAP repeat-containing protein 2; C-IAP1; Cellular inhibitor of apoptosis 1; hIAP-2; IAP homolog B; IAP-2; inhibitor of apoptosis protein; Inhibitor of apoptosis protein 2; mIAP-2; mIAP2; NFR2-TRAF signalling complex protein; RING finger protein 48; RING-type E3 ubiquitin transferase BIRC2; TNFR2-TRAF-signaling complex protein 2; unnamed protein product
基因别名: API1; Api2; AW146227; BIRC2; Birc3; c-IAP1; cIAP1; cIAP2; Hiap-2; HIAP1; HIAP2; IAP1; IAP2; mcIAP1; MIAP1; MIAP2; MIHB; MIHC; rIAP1; RNF48
UniProt ID: (Human) Q13490, (Mouse) Q62210
Entrez Gene ID: (Human) 329, (Mouse) 11797, (Rat) 60371